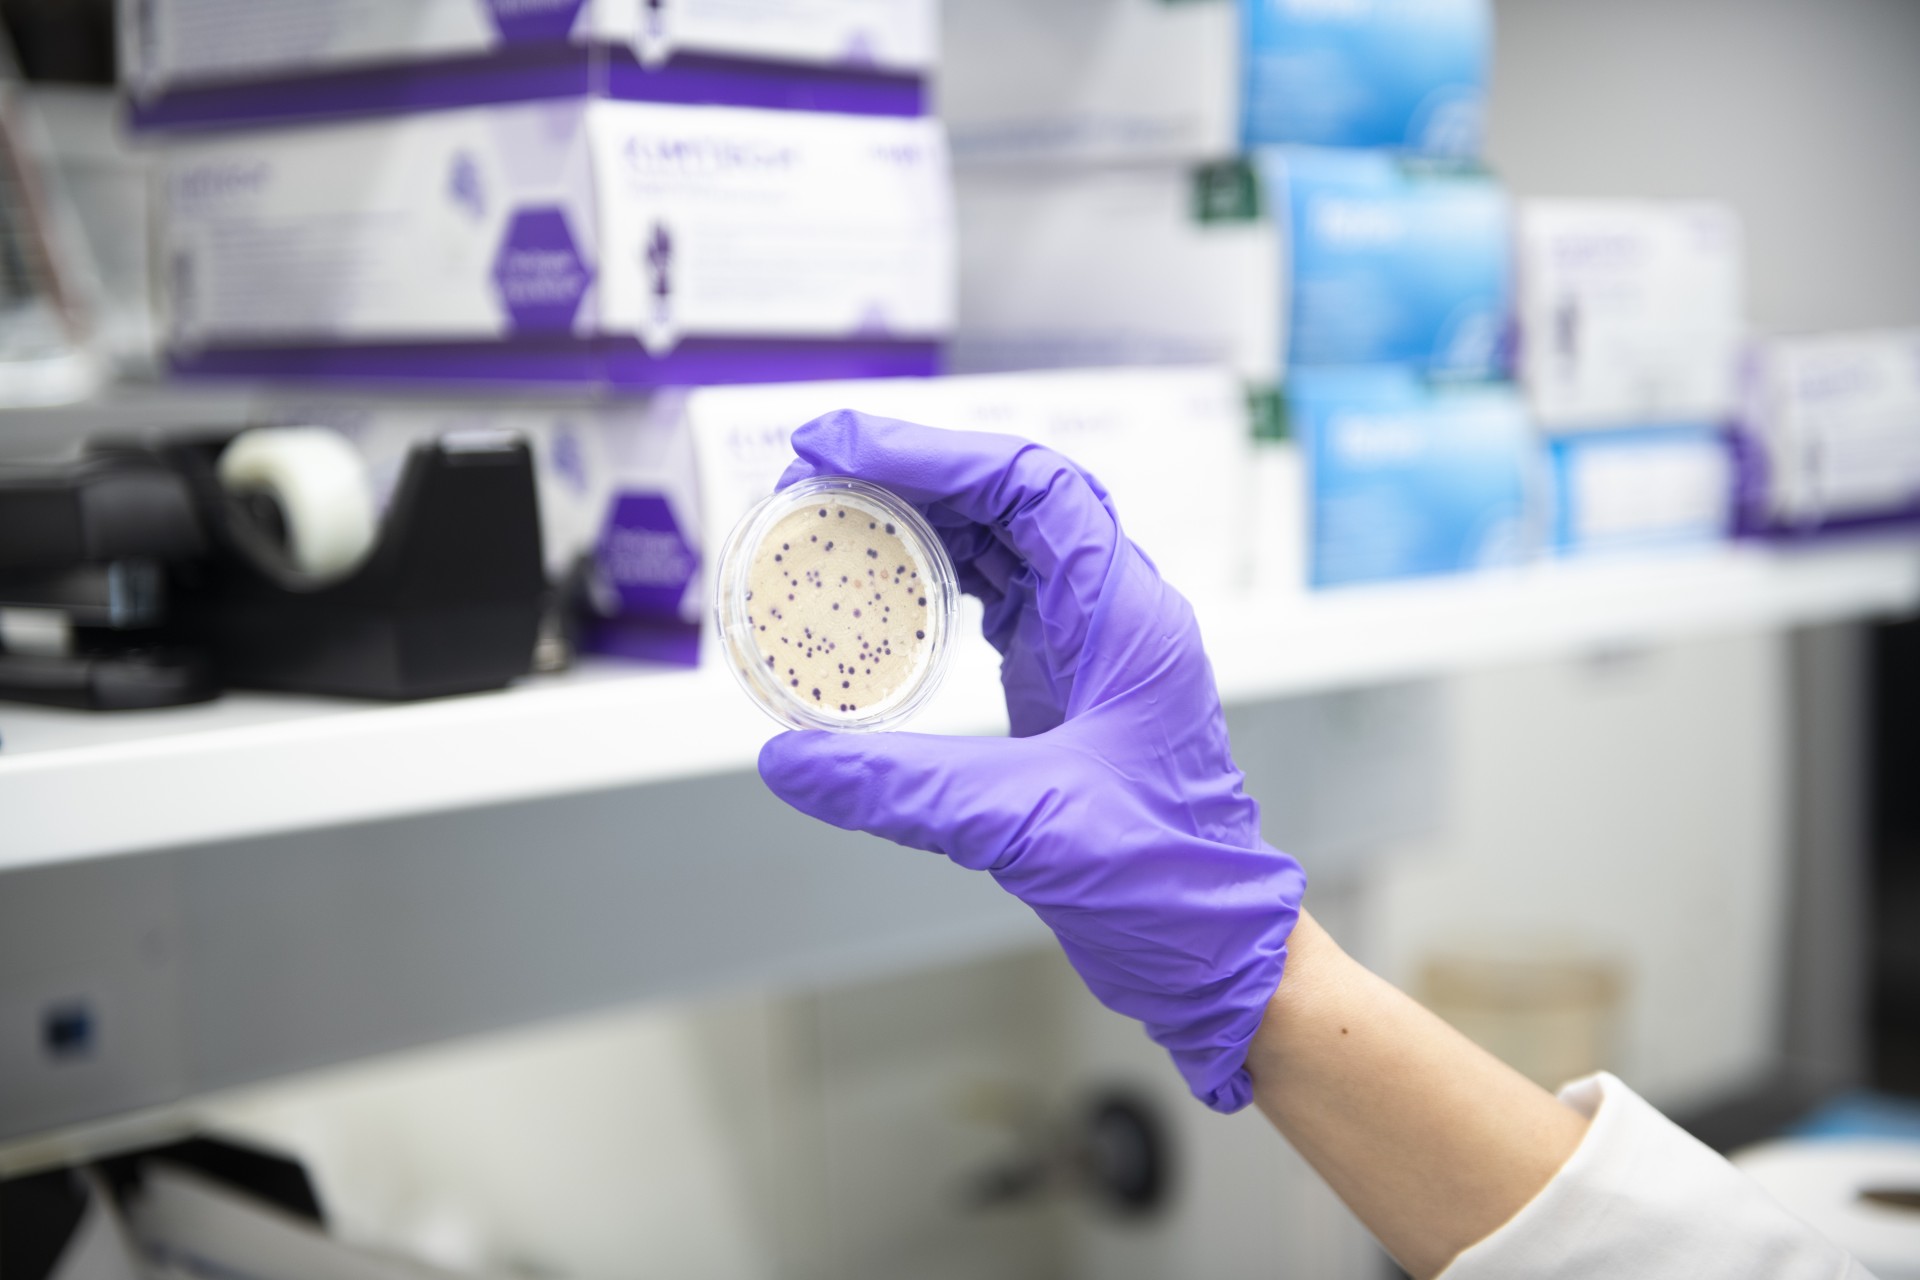

Estuary of Echoes
Scientific Environmental Research as a Multi-sensory Artistic Experience
This project explores the possibility of art and music as a means of sensing and communicating the change and health of aquatic environments in a manner that resonates emotionally with the audience. A multi-sensory approach is employed, using video, imagery, scent, and chemical reactions to analyze, visualize, and sonify data obtained from field research. The data is transformed into graphic and musical art forms, and played on timeless acoustic mechanisms such as chimes and music.
The results of the collaboration provide a unique, multidimensional experience for the audience, enabling a deeper understanding and awareness of the invisible and inaudible changes in aquatic environments. The study aims to make a contribution to the field of environmental conservation by utilizing art and music as a tool for promoting awareness and inspiring action.
Water Stories
June 8, 2024 – May 3, 2025
Saturday, June 8, 2024,
5 – 8 PM
Saturday, May 3, 2025
Exhibition InfoYoko Shimizu is an artist and researcher with a background in biology and chemistry, based in Linz, Austria, and Tokyo, Japan. Born in Kyoto and raised in the United States, she was inspired by the traditional art and nature of Kyoto and the contemporary art scene in New York as a child. To pursue her passion for science, she studied Biology and Chemistry at Kobe University. Her career began as a creative director and consultant in an advertising company. She then established her own creative innovation lab in Japan.
Yoko has gained recognition for biology-inspired installations that integrate art and science, and she has held exhibitions in countries around the globe. Her artworks are featured in museums such as the Museum of Contemporary Art Tokyo (MOT), Today Art Museum (TAM), Museum of Design Atlanta (MODA), and the Ars Electronica Center (Austria). Her work has also been showcased on various media platforms, including the BBC and Japan Television.
In addition to her artistic pursuits, Yoko has experience as a talk show host on international art and music programs in Japan. She has delivered talks and performances at global events such as TEDx, FITC, and Ars Electronica Festival. Yoko is the founder and director of the Matsudo International Science Art Festival and a co-founder of Beyond Earth.
Currently, she serves as an artist, key researcher, and Head of Creative Business Innovation at the Ars Electronica Futurelab in Linz, Austria. In this role, she leads creative innovation projects for corporations and government organizations worldwide. This involves ideation, conceptualization, R&D, prototyping, design, exhibition, presentation, performance, as well as engaging in social dialogue and outreach.
Website I